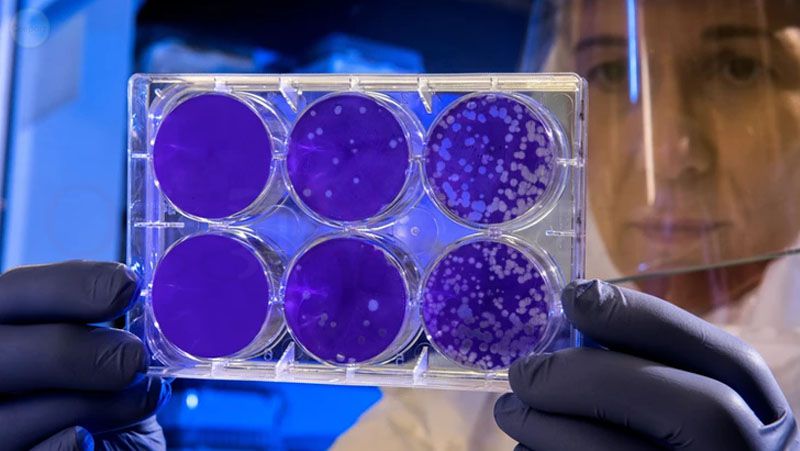

SOSTIENI LA LIBERA INFORMAZIONE
Gli articoli pubblicati si sostengono grazie alle vostre offerte, grazie a voi possiamo ogni giorno riportare notizie che il mainstream non da o nasconde, se lo desiderate potete aiutarci a tenere in piedi questo blog con un offerta. Clicca qui
Articolo tradotto
“Se l’erosione immunitaria si verifica dopo due dosi e solo pochi mesi, come possiamo escludere la possibilità che gli effetti di un “booster” non testato non si corrodano più rapidamente e in misura maggiore?”
Uno studio di Lancet che ha confrontato le persone vaccinate e non vaccinate in Svezia è stato condotto su 1,6 milioni di individui in nove mesi. Ha mostrato che la protezione contro il COVID-19 sintomatico è diminuita nel tempo, tanto che entro sei mesi alcuni dei gruppi vaccinati più vulnerabili erano maggiormente a rischio rispetto ai loro coetanei non vaccinati.
I medici chiamano questo fenomeno nella vaccinazione ripetuta “erosione immunitaria” o “immunodeficienza acquisita”, spiegando l’elevata incidenza di miocardite e altre malattie post-vaccino che li colpiscono più rapidamente, provocando la morte, o più lentamente, con conseguente cronicizzazione malattia.
I vaccini COVID non sono vaccini tradizionali. Piuttosto, fanno sì che le cellule riproducano una porzione del virus SARS-CoV-2, la proteina spike. I vaccini quindi inducono il corpo a creare proteine spike. Una persona crea solo anticorpi contro questa porzione limitata (la proteina spike) del virus. Ciò ha diversi effetti deleteri a valle.
In primo luogo, questi vaccini “addestrano male” il sistema immunitario a riconoscere solo una piccola parte del virus (la proteina spike). Varianti che differiscono, anche leggermente, in questa proteina sono in grado di sfuggire al ristretto spettro di anticorpi creato dai vaccini.
In secondo luogo, i vaccini creano “dipendenti dai vaccini”, il che significa che le persone diventano dipendenti da regolari iniezioni di richiamo, perché sono state “vaccinate” solo contro una piccola parte di un virus mutante. Il ministro della Salute australiano, il dottor Kerry Chant, ha dichiarato che il COVID sarà con noi per sempre e che le persone “dovranno abituarsi” a vaccinarsi senza fine. “Questo sarà un ciclo regolare di vaccinazione e rivaccinazione”.
In terzo luogo, i vaccini non prevengono l’infezione del naso e delle vie aeree superiori e gli individui vaccinati hanno dimostrato di avere cariche virali molto più elevate in queste regioni. Ciò porta i vaccinati a diventare “super-diffusori” poiché trasportano cariche virali estremamente elevate.
Inoltre, i vaccinati si ammalano più clinicamente dei non vaccinati. La Scozia ha riferito che il tasso di mortalità per infezione nei vaccinati è 3,3 volte quello dei non vaccinati e il rischio di morte se ricoverati in ospedale è 2,15 volte quello dei non vaccinati.
Un rapporto di giugno su Channel 12 News di Israele ha rivelato che nei mesi successivi al lancio dei vaccini, 6.765 persone che hanno ricevuto entrambi i colpi avevano contratto il coronavirus, mentre la tracciabilità epidemiologica ha rivelato che altre 3.133 persone hanno contratto COVID-19 da quegli individui vaccinati.
Nel frattempo, i ricercatori del New England Journal of Medicine hanno scoperto che la risposta autoimmune alla proteina spike del coronavirus può durare indefinitamente: “Gli anticorpi Ab2 che si legano al recettore originale sulle cellule normali hanno quindi il potenziale per mediare effetti profondi sulla cellula che potrebbero causare cambiamenti patologici , in particolare a lungo termine, molto tempo dopo che l’antigene originale stesso è scomparso”. Questi anticorpi prodotti contro la proteina spike del coronavirus potrebbero essere responsabili dell’attuale ondata senza precedenti di miocardite e malattie neurologiche, e anche di altri problemi in futuro.
CONTINUA A LEGGERE
Siamo entusiasti di comunicarvi la partnership tra Oggi Notizie e Anime Libere, un social libero da CENSURE, Intelligenza Artificiale, e algoritmi di controllo. Con il nuovo social Anime Libere hai la possibilità di pubblicare tu stesso notizie e argomenti di tuo interesse, aprire gruppi pubblici o privati e interagire con tutti gli iscritti attraverso una chat in tempo reale. Anime Libere preserva e promuove la possibilità di esprimersi e condividere opinioni, incoraggiando una discussione rispettosa e civile tra gli utenti.
Anime Libere non solo è totalmente gratuito, ma chi volesse sostenere il progetto sottoscrivendo un abbonamento avrà la possibilità di GUADAGNARE invitando amici ad iscriversi e monetizzare tramite i contenuti che pubblicherà